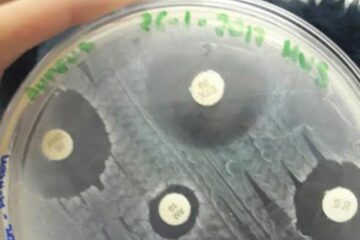
Antibiograma. Foto: microbiolofia 2017

Milioane de oameni, și mai ales femei, care suferă de infecții urinare, vor putea beneficia în curând de protecția unui vaccin.
Cercetătorii de Universitatea din Michigan, Statele Unite, au publicat recent în revista PLos Pathogens rezultatele obținute pe șoareci, care au prezentat o puternică rezistență imunitară la bacteria Escherichia coli, principala responsabilă pentru aceste patologii deosebit de deranjante.
În Statele Unite, 53 la sută dintre femei și 14 la sută dintre bărbați sunt victimele acestei infecții cel puțin o dată în viață.
Pentru a încerca să lupte împotriva acestui flagel, echipa de cercetători condusă de Dr. Harry Mobley a selecționat șase proteine bacteriene care au dat un răspuns imunitar, dintre cele 5.379 studiate. Iar trei dintre aceste substanțe, injectate în mucoasa nazală a șoarecilor, au permis acestor mici rozătoare să nu contacteze infecții urinare.
Potrivit Dr. Mobley, proteinele acționează pe receptorii situați pe suprafața bacteriei, care joacă un rol important în extinderea infecției.
Înainte ca aceste vaccinuri să fie aplicate oamenilor, vor trebui efectuate teste clinice, și abia peste câțiva ani vor putea fi comercializate.